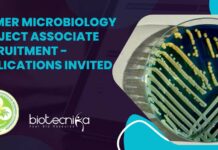
PGIMER Microbiology Project Associate

Home 2024
Yearly Archives: 2024
Novartis BSc & MSc Biology Specialist Role – Apply Online
Novartis Biology Specialist Job Opening - Apply Online
Senior Specialist:
Job ID: REQ-10014795
Date: Sep 03, 2024
Location: India
Summary
Senior Specialist, ORE, supports the process of outsourcing scientific activities...
Remote Jobs at Parexel For Biological Sciences – Apply For Study Grant Analyst Role
Parexel Clinical Research Vacancies - Fully Remote Job For Biological Sciences
Study Grant Analyst II
India, Remote
Additional Locations: Bengaluru, Karnataka, India
Job ID: R0000025185
Category: Administrative
About this Role
Key...
Fully Remote Jobs at Novonesis For Food Tech, Biotech – Apply Online
Food Technology Job Vacancy at Novonesis - Fully Remote Opportunity
Jr Executive Formulation
Remote type: Full Remote
Locations: Tal-Khalapur, Mumbai
Time type: Full time
Posted on: Posted Today
Job Requisition...
Shiv Nadar University DBT-Funded JRF Job For MSc Life Sciences – Apply Now
Research Fellowship at SNU For MSc Life Sciences - Apply Now
Junior Research Fellowship JRF in DBT Project
Job Details
Position: Junior Research Fellowship
Job Id: 3548
School: School...
CSIR-IICT Bioinformatics, Biotech, Life Sciences, Mol Bio Project Jobs – Attend Walk-In
CSIR-IICT Bioinformatics, Biotech, Life Sciences, Mol Bio Project Jobs - Attend Walk-In
CSIR-IICT Bioinformatics, Biotech, Life Sciences, Mol Bio Project Jobs - Attend Walk-In. Interested...
Biotecnika Times Newsletter 04.09.2024 – BRIC-NII Research Intern, NCBS-TIFR High Pay Job, Data Science...
BRIC-NII Research Intern For Biological Sciences With Monthly Fellowship - Apply Now
Apply now for a research internship with a monthly fellowship at BRIC NII,...
BRIC-NII Research Intern For Biological Sciences With Monthly Fellowship – Apply Now
BRIC-NII Research Intern For Biological Sciences With Monthly Fellowship - Apply Now
BRIC-NATIONAL INSTITUTE OF IMMUNOLOGY
ARUNA ASAF ALI MARG, NEW DELHI
ADVERTISEMENT FOR WALK-IN-INTERVIEW
Name of the...
MAHE Manipal ICMR-Funded Project Staff Recruitment For Life Sciences – Applications Invited
MAHE Manipal Project Staff Recruitment For Life Sciences - Applications Invited
Manipal Academy of Higher Education (MAHE), Manipal invites applications from eligible candidates for Research...
ICMR-NIRRCH Biological Science Project Assistant Recruitment – Attend Walk-In
NIRRCH Biological Science Project Assistant Recruitment - Attend Walk-In
ICMR-National Institute for Research in Reproductive and Child Health
Indian Council of Medical Research
Jehangir Merwanji Street, Parel,...
Worlds First Artificial Intelligence-Driven Oral Cancer Database Developed by Jamia Millia Islamia
Worlds First Artificial Intelligence-Driven Oral Cancer Database Developed by Jamia Millia Islamia
JMI develops the world’s first Artificial Intelligence Driven Oral Cancer Database
A significant advancement...
PGIMER Microbiology Project Associate Recruitment – Applications Invited
PGIMER Microbiology Project Associate Recruitment - Applications Invited
DEPARTMENT OF PULMONARY MEDICINE
POSTGRADUATE INSTITUTE OF MEDICAL EDUCATION AND RESEARCH, CHANDIGARH
Applications are invited for (a) one post...
AIIMS Delhi DBT-Funded Senior Research Fellow Recruitment – Apply Now!
AIIMS Delhi Research Opportunity For Biotech & Life Sciences, Apply Now
Advertisement
Applications are invited for one temporary position for a DBT funded research project (BT-2222)...
Presidency University Hiring! Apply For JRF Post – MSc Life Sciences Eligible
Presidency University Hiring Apply For JRF Post - MSc Life Sciences Eligible
Advertisement for the position of a Junior Research Fellow at Institute of Health...
Research Assistant at AICCRS, Amity University! BSc, MSc & MTech Biological Sciences Apply Now!
AICCRS Biological Sciences Research Assistant Job Opening - Apply Online
Applications invited for Research Assistant at AICCRS, Amity University Noida - 04-09-2024 - Adv/AUUP/HR/24/56
Advertisement Date:...
Novartis Medical Scientific Liaison For Life Sciences! Apply Now!
Novartis Medical Scientific Liaison For Life Sciences! Apply Now!
Medical Scientific Liaison
Job ID REQ-10015326
Sep 02, 2024
India
Summary
Lead scientific engagement with their Medical Experts. Implement clinical and...